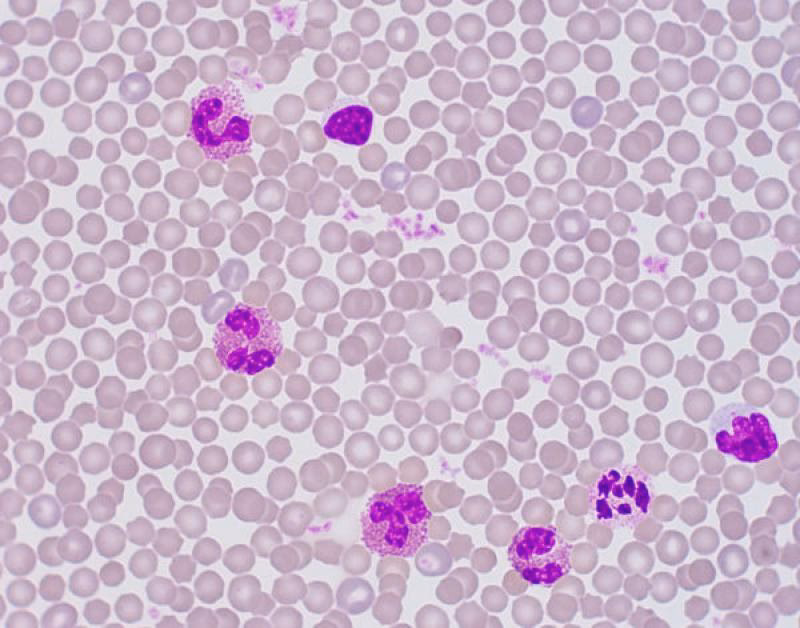
¿Qué células presenta la sangre?

11/03/2026
Los conejos son maestros en ocultar los signos de enfermedad, lo que a menudo dificulta la detección temprana de problemas de salud. Es por ello que las pruebas de laboratorio, como los análisis de sangre, se convierten en herramientas invaluables para obtener información sobre su estado interno. Comprender la composición y morfología de la sangre de un conejo es fundamental para interpretar estos resultados y proporcionar el mejor cuidado posible a nuestra mascota.
La sangre es un tejido líquido complejo que circula por el cuerpo, transportando nutrientes, oxígeno y células encargadas de la defensa y otras funciones vitales. En los conejos, al igual que en otros mamíferos, está compuesta principalmente por plasma y células sanguíneas: glóbulos rojos (eritrocitos), glóbulos blancos (leucocitos) y plaquetas (trombocitos). Los eritrocitos, o glóbulos rojos, de los conejos son células típicas de mamíferos: anucleadas (sin núcleo) y con forma de disco bicóncavo. Su tamaño promedio es de aproximadamente 6.8 μm, situándose entre el tamaño de los glóbulos rojos de perros y gatos. Sin embargo, el rango de tamaño de los eritrocitos de conejo es bastante amplio, variando entre 5.0 y 7.8 μm. Esta variación en el tamaño individual de las células es lo que a menudo se reporta como una marcada anisocitosis en los análisis de sangre. A diferencia de los carnívoros domésticos, donde la anisocitosis suele indicar la presencia de reticulocitos (glóbulos rojos jóvenes) y sugiere una anemia regenerativa, en los conejos, una anisocitosis leve a moderada se considera una característica normal debido a la variación inherente en el tamaño celular. La vida útil de los eritrocitos de conejo es relativamente corta, alrededor de 57 días, lo que se traduce en una alta tasa de recambio celular. Esta alta renovación se refleja en la presencia normal de un cierto grado de policromasia (glóbulos rojos con una tinción ligeramente azulada, indicando inmadurez) en los frotis sanguíneos. La policromasia en conejos, dentro de ciertos límites, no suele tener significado clínico. Otra particularidad de los eritrocitos de conejo es la presencia ocasional de cuerpos de Howell-Jolly (pequeños fragmentos nucleares remanentes) y de algunos glóbulos rojos nucleados (1-2 por cada 100 leucocitos). Estos hallazgos, en número reducido, se consideran dentro del rango de referencia normal para la especie y no son necesariamente indicadores de regeneración celular como en otras especies.
Glóbulos Rojos (Eritrocitos): Forma, Tamaño y Particularidades
La sangre contiene muchos tipos de células: glóbulos blancos (monolitos, linfocitos, neutrófilos, eosinófilos, basófilos y macrófagos), glóbulos rojos (eritrocitos) y plaquetas.
La sangre contiene muchos tipos de células: glóbulos blancos (monolitos, linfocitos, neutrófilos, eosinófilos, basófilos y macrófagos), glóbulos rojos (eritrocitos) y plaquetas.
Anemia en Conejos: Causas y Tipos
Una disminución significativa en el número de glóbulos rojos, hemoglobina o el volumen de células empaquetadas (PCV) se considera anemia. El rango de referencia publicado para el PCV en conejos es de 30% a 50%, aunque en conejos de compañía a menudo se observan valores ligeramente inferiores, entre 30% y 40%. Un PCV inferior al 30% generalmente indica anemia, especialmente si los recuentos de glóbulos rojos y hemoglobina también son bajos.
La anemia en conejos puede clasificarse en dos tipos principales:
- Anemia No Regenerativa: Es común en conejos de compañía y suele estar asociada con enfermedades crónicas. Ejemplos incluyen infecciones crónicas como otitis media, enfermedad dental (con o sin abscesos), neumonía, pododermatitis, mastitis, endometritis y piometra, enfermedad renal y osteomielitis. En estos casos, la médula ósea no responde adecuadamente a la necesidad de producir más glóbulos rojos.
- Anemia Regenerativa: Se manifiesta por una producción rápida y significativa de reticulocitos (glóbulos rojos jóvenes) y generalmente indica pérdida de sangre. Las causas de hemorragia externa pueden ser traumas o infestaciones severas por pulgas. Las causas internas comunes incluyen hematuria (sangre en la orina) debida a cálculos renales o vesicales, o sangrado de adenocarcinomas uterinos o aneurismas endometriales en hembras. La hemólisis intravascular (destrucción de glóbulos rojos dentro de los vasos sanguíneos) es una causa menos común, que puede ocurrir tras la ingestión de ciertas plantas (patatas, cebollas, ajos, cebolletas), causando anemia por cuerpos de Heinz. La toxicosis por plomo también puede causar anemia regenerativa, caracterizada por glóbulos rojos nucleados en abundancia, hipocromasia (poca hemoglobina), poiquilocitosis (formas anormales) y punteado basófilo. La anemia hemolítica autoinmune es rara pero se ha reportado.
Glóbulos Blancos (Leucocitos): El Sistema de Defensa
Los leucocitos, o glóbulos blancos, son las células responsables de la respuesta inmune y la defensa del cuerpo contra patógenos e inflamación. Un recuento diferencial de glóbulos blancos, que identifica y cuantifica cada tipo de leucocito, junto con la evaluación de su morfología en un frotis sanguíneo bien preparado, es esencial para evaluar el estado de salud general del paciente y desarrollar una lista de posibles diagnósticos.
Es importante notar que la interpretación de los datos de glóbulos blancos en conejos difiere de la de otras especies domésticas como perros y gatos, donde la leucocitosis (aumento del número total de glóbulos blancos) es una respuesta típica a la inflamación. En conejos, aunque la leucocitosis puede observarse en casos de linfosarcoma, no es la respuesta habitual a la inflamación.
Tipos de Leucocitos y su Función en Conejos
La sangre de conejo presenta varios tipos de leucocitos, cada uno con morfología y función específicas:
- Neutrófilos (Heterófilos): Son células redondeadas de 10 a 15 μm de diámetro. Su núcleo está claramente segmentado y se tiñe de un color azul-púrpura intenso. El citoplasma es claro y contiene un número variable de gránulos que varían en tamaño y color (pequeños y rosados, o grandes y rojizos). Debido a la intensa tinción rosa a roja de sus gránulos, a menudo se les denomina heterófilos o acidófilos en los informes de laboratorio de conejos. Es crucial entender que, independientemente de cómo se les llame, no hay diferencia funcional entre los neutrófilos de conejo y los de otras especies.
- Linfocitos: Los conejos tienen dos poblaciones distintas de linfocitos: pequeños (7-10 μm) y grandes (10-15 μm). Son células redondas con un núcleo redondo o ligeramente ovalado de color púrpura intenso. El citoplasma es escaso o ausente en los linfocitos pequeños y más abundante y azulado en los grandes. Algunos linfocitos grandes pueden presentar un halo claro alrededor del núcleo e incluso algunos gránulos azurófilos. Son fundamentales en la respuesta inmune adaptativa.
- Eosinófilos: Miden de 10 a 16 μm de diámetro y tienen un núcleo púrpura bilobulado o en forma de herradura. Su citoplasma está lleno de tantos gránulos que la célula adquiere un aspecto naranja-rosa y espumoso. La abundancia de gránulos es la principal diferencia morfológica con los neutrófilos. Su función más importante es la eliminación de histamina y toxinas similares a la histamina, sugiriendo un papel en el control de reacciones alérgicas, abscesos y cicatrización de heridas. A diferencia de otras especies, la eosinofilia en conejos rara vez está ligada a enfermedades parasitarias (excepto cuando las larvas migran por los tejidos), y Encephalitozoon cuniculi no estimula una respuesta eosinofílica. Un recuento muy bajo, incluso cero, es común en conejos clínicamente sanos.
- Monocitos: Son los leucocitos más grandes, con un diámetro promedio de 15 a 18 μm. Su núcleo púrpura suele ser lobulado, pero puede tener forma de herradura o frijol. Los monocitos tienen más citoplasma que los linfocitos, y su citoplasma se tiñe de un color azul-gris jaspeado. Están asociados con la inflamación crónica (por ejemplo, abscesos, mastitis, empiema de la bulla timpánica). Sin embargo, la ausencia de monocitosis no descarta la inflamación; es común encontrar recuentos de monocitos dentro del rango normal en conejos con osteomielitis debida a enfermedad dental.
- Basófilos: Miden de 8 a 12 μm de diámetro. Su núcleo está menos segmentado que el de los eosinófilos o heterófilos y es difícil de ver debido a los numerosos gránulos de color púrpura intenso que oscurecen el citoplasma gris claro. Al igual que en otras especies, la función de los basófilos de conejo no se comprende completamente, pero estas células a menudo están presentes en gran número en los frotis de sangre de conejo. Se ha descrito basofilia con eosinofilia concurrente en conejos con problemas cutáneos crónicos.
Aquí tienes un resumen de los tipos de glóbulos blancos de conejo:
| Tipo de Leucocito | Tamaño (μm) | Morfología del Núcleo | Morfología del Citoplasma | Función/Asociación Principal |
|---|---|---|---|---|
| Neutrófilo (Heterófilo) | 10-15 | Segmentado, púrpura intenso | Claro, gránulos rosados/rojizos | Respuesta inmune temprana, fagocitosis, inflamación aguda. Respuesta al estrés. |
| Linfocito | 7-15 (pequeños y grandes) | Redondo/ovalado, púrpura intenso | Escaso (pequeños) a abundante azulado (grandes) | Inmunidad adaptativa (células B, T), respuesta viral y crónica. Afectado por estrés. |
| Eosinófilo | 10-16 | Bilobulado/herradura, púrpura | Abundante, gránulos naranja-rosa espumosos | Reacciones alérgicas, respuesta a histamina, abscesos, cicatrización. |
| Monocito | 15-18 | Lobulado/herradura/frijol, púrpura | Abundante, azul-gris jaspeado | Fagocitosis, presentación de antígenos, inflamación crónica. |
| Basófilo | 8-12 | Poco segmentado, oscurecido por gránulos | Gris claro, gránulos púrpura intenso | Función poco clara, reacciones alérgicas crónicas (con eosinofilia). |
Interpretación del Recuento de Glóbulos Blancos: Consideraciones Únicas
Como se mencionó, la interpretación de los recuentos de glóbulos blancos en conejos puede ser un desafío porque no siempre responden a la inflamación con leucocitosis como en perros o gatos. Los estudios han demostrado que la inyección de bacterias o levaduras puede causar fiebre, aumento de cortisol, neutrofilia (aumento de neutrófilos) y linfopenia (disminución de linfocitos), pero no necesariamente un aumento en el número total de leucocitos circulantes.
En la práctica clínica, los conejos con sepsis pueden mostrar respuestas variadas, incluyendo neutropenia (disminución de neutrófilos), recuento neutrofílico normal o una neutrofilia madura que represente más del 90% de los glóbulos blancos. La presencia de neutrófilos en banda (formas inmaduras, un indicador de "desviación a la izquierda" en otras especies) parece ser rara en conejos con infección clínica, por lo que su ausencia no descarta un problema infeccioso.
Una alteración en la relación neutrófilo/linfocito que muestre una neutrofilia relativa junto con linfopenia puede ser un indicador de respuesta a la infección o, de manera muy importante, al estrés. Esta relación es aproximadamente 1:1 en un conejo adulto sano.

El estrés es un factor crucial que puede alterar el recuento diferencial de glóbulos blancos. El transporte, la espera en un entorno desconocido, ruidos extraños, o incluso la contención para el examen clínico pueden cambiar esta relación. El manejo suave no parece inducir esta respuesta, pero el estrés más prolongado, como un viaje largo o la exposición a perros ladrando en la sala de espera, puede inducir linfopenia y neutrofilia relativa que pueden persistir hasta por 24 a 48 horas.
El recuento total de glóbulos blancos puede ayudar a diferenciar el estrés agudo del estrés crónico (por ejemplo, malnutrición, manejo inadecuado, estrés social prolongado, enfermedad dental), ya que tanto la leucopenia como la linfopenia son más comunes con el estrés crónico.
La linfopenia, en particular, a menudo se asocia con el estrés crónico debido al aumento de los niveles de cortisol. Por el contrario, un aumento en los niveles de adrenalina (estrés agudo) puede inducir linfocitosis. Las enfermedades virales, el linfoma y la intoxicación por plomo también pueden causar linfocitosis.
Factores que Afectan los Parámetros Sanguíneos
Diversos factores fisiológicos y externos pueden influir en los recuentos y la morfología de las células sanguíneas en conejos, lo que complica su interpretación:
- Edad: Los conejos menores de 12 semanas suelen tener recuentos más bajos de glóbulos rojos y blancos.
- Sexo y Raza: Pueden existir variaciones, aunque la información disponible en conejos de compañía es limitada.
- Ritmos Circadianos: El recuento total de glóbulos blancos y linfocitos es más bajo al final de la tarde y por la noche, mientras que los heterófilos y eosinófilos aumentan.
- Estrés: Como se detalló anteriormente, el estrés, tanto agudo como crónico, tiene un impacto significativo en el recuento de glóbulos blancos, especialmente en la relación neutrófilo/linfocito. El estrés prolongado puede llevar a linfopenia y leucopenia general.
- Manejo y Contención: La contención física, especialmente en conejos reacios o no acostumbrados, puede elevar enzimas musculares como la creatina quinasa (CK) y la AST, aunque no afecta directamente los recuentos celulares si el manejo es suave.
- Hemólisis: La ruptura de glóbulos rojos (hemólisis), ya sea por problemas en la toma de muestra o en el manejo de la muestra, puede alterar artificialmente muchos parámetros, incluyendo una disminución aparente en el recuento de glóbulos rojos y un aumento en los niveles de potasio y ciertas enzimas.
- Dieta y Estado Nutricional: Una dieta inadecuada o la malnutrición crónica (a menudo secundaria a problemas dentales o de manejo) pueden afectar negativamente los recuentos de glóbulos rojos (anemia) y los niveles de proteínas, lo que a su vez influye en el transporte de ciertas sustancias en la sangre.
El Volumen Sanguíneo del Conejo
Además de la composición celular, es útil conocer el volumen total de sangre que posee un conejo. El volumen sanguíneo de un conejo sano es de aproximadamente 55 a 65 mL por kilogramo de peso corporal. Para la toma de muestras, se puede recoger de forma segura entre el 6% y el 10% del volumen sanguíneo total del animal. Conocer este dato es importante para el veterinario al decidir la cantidad de sangre a extraer y evaluar el riesgo de anemia iatrogénica (causada por la extracción).
Preguntas Frecuentes sobre la Sangre del Conejo
Aquí respondemos algunas dudas comunes basadas en la información proporcionada:
- ¿Por qué es difícil interpretar los análisis de sangre en conejos? La interpretación es compleja porque muchos rangos de referencia provienen de estudios en conejos de laboratorio homogéneos, que difieren de la población heterogénea de conejos de compañía. Además, los conejos ocultan los signos de enfermedad, lo que significa que incluso una muestra de un conejo aparentemente sano puede mostrar cambios debidos a problemas crónicos subyacentes (malnutrición, manejo inadecuado, estrés).
- ¿La anisocitosis en conejos es siempre signo de enfermedad? No, una anisocitosis marcada es común en conejos sanos debido a la variación normal en el tamaño de sus glóbulos rojos. No necesariamente indica anemia regenerativa como en perros o gatos.
- ¿Son normales los cuerpos de Howell-Jolly o los glóbulos rojos nucleados? La presencia de algunos cuerpos de Howell-Jolly y un número muy pequeño de glóbulos rojos nucleados (1-2 por cada 100 leucocitos) se considera dentro del rango normal en conejos sanos y no indica necesariamente regeneración celular.
- ¿Cuál es la diferencia entre neutrófilos y heterófilos? En conejos, los neutrófilos a menudo se llaman heterófilos o acidófilos debido a la coloración intensa de sus gránulos. Sin embargo, funcionalmente, son equivalentes a los neutrófilos de otras especies.
- ¿Cómo afecta el estrés a los resultados de sangre? El estrés, especialmente el crónico, puede causar linfopenia y neutrofilia relativa, alterando la relación neutrófilo/linfocito. El estrés prolongado también puede llevar a leucopenia y linfopenia generales. El estrés agudo puede causar linfocitosis debido a la adrenalina.
- ¿La leucocitosis siempre indica infección en conejos? No, a diferencia de perros y gatos, la leucocitosis no es la respuesta inflamatoria típica en conejos (excepto quizás en linfosarcoma). Las infecciones a menudo causan cambios en los subtipos de glóbulos blancos (neutrofilia, linfopenia) sin un aumento en el total.
Comprender la morfología y las particularidades de las células sanguíneas de los conejos, así como los factores que pueden influir en los resultados de los análisis, es un paso crucial para cualquier cuidador. Siempre es recomendable discutir los resultados del laboratorio con un veterinario especializado en conejos, quien podrá interpretarlos en el contexto del historial clínico y examen físico de tu mascota, brindando así la atención más precisa y adecuada.
Si quieres conocer otros artículos parecidos a La Sangre del Conejo: Células y Significado puedes visitar la categoría Conejos.
